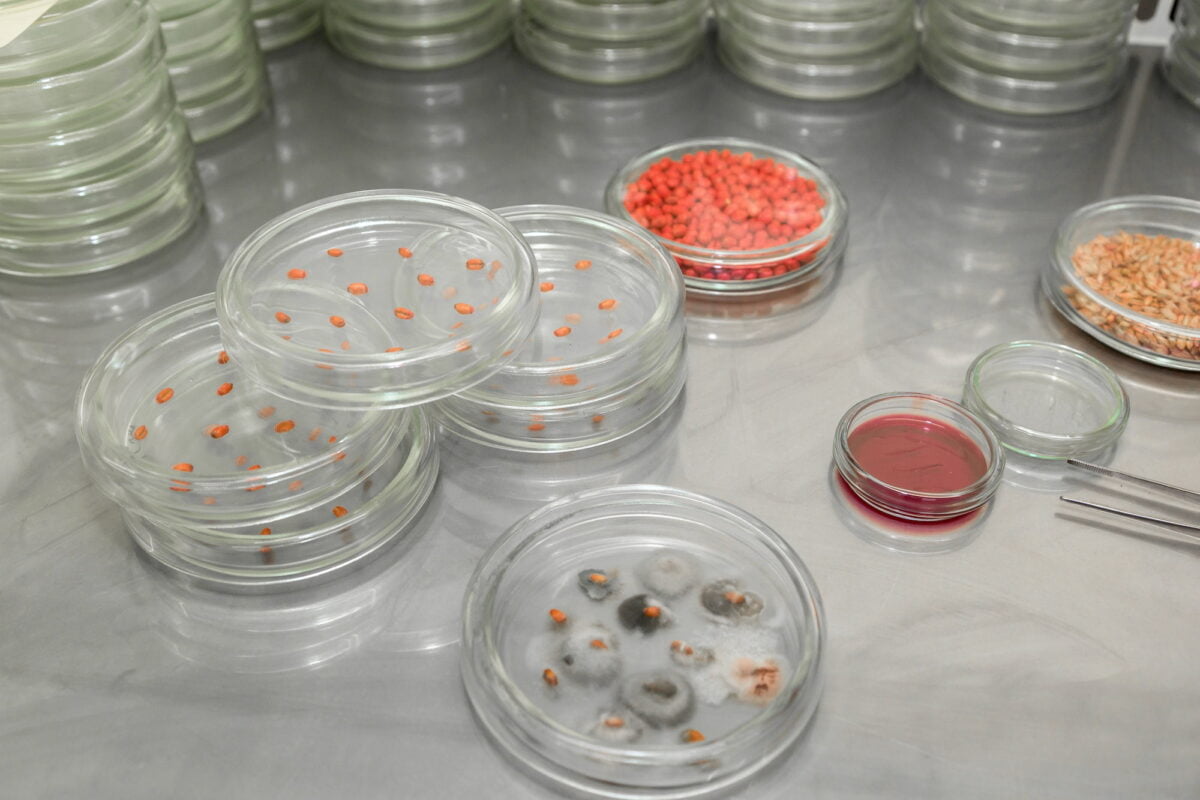

Les infections fongiques, comprenez des maladies provoquées par des champignons, sont à l’origine de plus de 1,5 million de morts dans le monde chaque année et menacent de résister aux médicaments. Dans le même temps, le réchauffement climatique est un problème majeur qui a des répercussions considérables tout autour du globe.
Ces deux phénomènes semblent n’avoir aucun rapport entre eux, mais peuvent-ils être liés ? Les zombies existent-ils vraiment ? Et pourquoi la série The Last of Us est-elle si proche de la réalité ? Voyons en quoi le réchauffement climatique influence la propagation des maladies fongiques.
Les maladies fongiques : une menace mondiale
Une infection fongique est une infection provoquée par des champignons microscopiques. Ces maladies peuvent être très graves pour les personnes dont le système immunitaire est affaibli. Il existe trois principaux types de champignons responsables des cas les plus graves : Candida, Aspergillus et Pneumocytis.
Aux États-Unis, elles sont à l’origine de 3 500 morts et 50 000 hospitalisations par an. Actuellement, il n’existe pas de vaccin contre les infections fongiques. Des scientifiques américains ont commencé à en développer un pour limiter les symptômes graves de ces affections. Ils ont effectué des tests sur des singes et des souris et les résultats sont encourageants.

Des fourmis zombies infectées par des champignons parasites
Si les scientifiques ont identifié environ 35 espèces de champignons ophiocordyceps capables de transformer des insectes en morts-vivants, il en existerait 600 en tout. Ces individus infectés présentent un comportement erratique et anormal, le champignon prenant contrôle de son hôte en développant des cellules autour de son cerveau.
Il pirate son système nerveux pour modifier ses muscles. Cependant, les chercheurs ignorent encore si le champignon libère des substances chimiques ou modifie l’ADN de l’insecte.
Dans le jeu de science-fiction The Last of Us, une épidémie fongique due à un champignon tueur milite à ravager le monde. Bien sûr, cela paraît invraisemblable, mais il existe bel et bien des champignons qui transforment des fourmis en zombies.
Le Cordyceps, qui a inspiré le jeu, est un exemple flagrant de ce phénomène. Ce champignon parasite les fourmis charpentières et atrophie leurs muscles, modifiant leur système nerveux central. En pratique, la fourmi oublie son chemin vers le nid et commence à marcher aléatoirement.
Ian Will, généticien spécialiste des champignons à l’université de Floride centrale, explique que ces champignons parasites et leurs hôtes évoluent ensemble depuis environ 45 millions d’années.
Le danger des champignons mutants
Même si cette histoire ne se produira sans doute jamais chez l’homme, la menace de voir les maladies dues aux champignons s’aggraver en raison du réchauffement des températures est prise très au sérieux. L’Organisation Mondiale de la Santé (OMS) s’inquiète de l’impact du changement climatique sur les infections fongiques et travaille à trouver des solutions. Par ailleurs, les espèces endémiques qui résistent naturellement aux maladies pourraient perdre leur protection et s’exposer à des infections mortelles.
Le risque d’une infection fongique chez l’Homme
Pour pouvoir infecter un animal à sang chaud, comme l’Homme, le champignon devrait subir une évolution importante sur de nombreuses années.
João Araújo, spécialiste des champignons parasites au Jardin botanique de New York, souligne que les effets des champignons sur nos organismes peuvent être très variés : allergies, brûlures et irritations cutanées, problèmes respiratoires et digestifs… Les mycoses qui touchent la peau sont les plus fréquentes et les plus connues. Toutefois, ce ne seront pas des zombies qui sortiront des forêts !
Quels risques de pandémie ?
Le Cordyceps est un champignon redoutable, mais on ne peut pas dire qu’il soit à l’origine d’une véritable pandémie.
Malheureusement, le réchauffement climatique a favorisé l’apparition de nouvelles espèces de champignons nuisibles et ainsi modifié l’écosystème. Certaines de ces espèces sont plus agressives et sont capables de coloniser plus facilement les terres arables.
Au cours des quinze dernières années, des chercheurs ont signalé que les principales infections fongiques augmentaient en intensité et en fréquence.
Des conséquences inquiétantes pour 2023
Si le réchauffement climatique continue à avoir lieu à un rythme ininterrompu, le volume des infections fongiques devrait encore augmenter. En 2023, les zones tropicales seront les plus touchées et les pays défavorisés les plus vulnérables.
Même si les scientifiques finissent par mettre au point un vaccin contre ces infections, il y aura toujours un risque de pandémie. Il est donc indispensable de protéger notre planète et de prendre conscience que le changement climatique est une menace réelle pour la santé publique.
Nous devons adopter des mesures concrètes pour lutter contre les effets néfastes du réchauffement climatique et pour empêcher les pandémies provoquées par les champignons.
- Protéger l’environnement : Plantation massive d’arbres, mise en place de programmes de recyclage, etc.
- Promouvoir les bonnes pratiques de santé : Hygiène personnelle, vaccination, respect des consignes sanitaires, etc.
- Favoriser la recherche médicale : Amélioration des techniques diagnostiques, innovations physiques et technologiques, nouveaux médicaments et vaccins, etc.
Prendre des mesures maintenant est essentiel pour sauver des vies et contrer le fléau des pandémies dues aux champignons.
Réchauffement climatique et propagation des champignons
Avec la hausse des températures, les infections fongiques risquent de se multiplier. Et parmi elles, les infections les plus graves qui touchent les immunodéprimés, peuvent menacer gravement leur survie.
Pour mesurer l’impact du réchauffement climatique sur la multiplication des champignons, les biologistes ont étudié ceux du genre Ophiocordyceps.
Résumé des principaux impacts des champignons sur notre santé :
- Allergies, brûlures et irritations cutanées
- Problèmes respiratoires et digestifs
- Mycoses touchant la peau
- Maladies graves pour les immunodéprimés
La propagation des champignons est influencée par le réchauffement climatique
Les chercheurs constatent que plus la température augmente, plus les champignons pathogènes peuvent se multiplier et se propager. Selon l’étude menée, 14 % des contaminations par le champignon étaient dues à un changement de température en 2018. Ce pourcentage devrait atteindre 23 % en 2023 et jusqu’à 33 % en 2050.
En conclusion, les champignons sont bien une menace potentielle pour la santé humaine, qui a tendance à s’amplifier avec le réchauffement climatique. Ils causent différentes affections allant des allergies aux maladies graves pour les immunodéprimés. Bien que les zombies ne soient pas à craindre, certains champignons parasites sont capables de prendre le contrôle de leur hôte. C’est pourquoi il est important de rester vigilant et d’adopter des comportements responsables pour limiter l’ampleur du phénomène.
Source :
- https://www.nouvelobs.com/sciences/20230210.OBS69437/pourquoi-les-champignons-peuvent-devenir-une-vraie-menace-meme-sans-nous-transformer-en-zombies.html
- https://www.caminteresse.fr/sante/pour-anticiper-une-epidemie-causee-par-des-champignons-dangereux-un-vaccin-est-a-letude-11187474/
- https://www.cnetfrance.fr/news/la-pandemie-fongique-de-the-last-of-us-est-elle-possible-dans-notre-monde-39952980.htm
- https://www.futura-sciences.com/planete/actualites/champignon-last-us-faut-il-avoir-peur-champignons-zombificateurs-103168/
- https://www.nationalgeographic.fr/sciences/2023/01/ce-champignon-parasite-pourrait-il-evoluer-pour-controler-les-humains